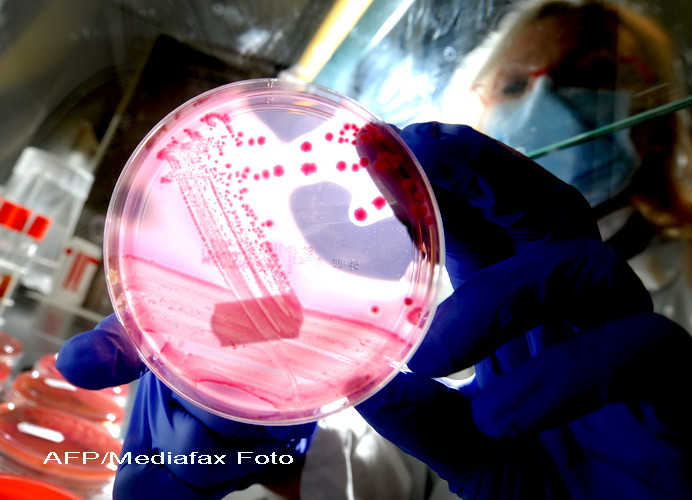
Cel mai contaminat loc din casa ta. Unde ai 8.000 de bacterii pe centimetrul patrat

O femeie cere despăgubiri de 230.000 de euro unei companii de brânzeturi, după ce soțul ei a murit în urma unei infecții
O femeie din Marea Britanie a intentat proces unei companii de brânzeturi, cerând despăgubiri de peste 200.000 de lire ...
Citeste mai mult ›
Citeste mai mult ›